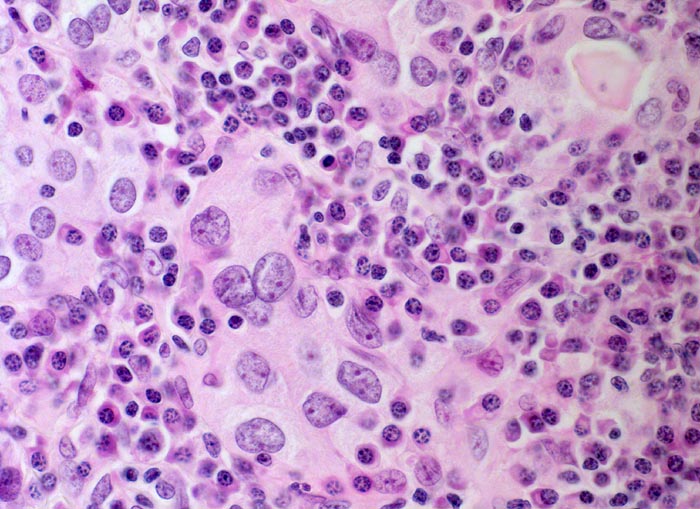

PathoPic – image database / PathoPic ID 4579 - chronische lymphozytäre Thyreoiditis Hashimoto
de
Diagnose
chronische lymphozytäre Thyreoiditis Hashimoto
Diagnose Gruppe
Systemerkrankung/Immunpathologie
Topographie
Schilddrüse
Topographie Gruppe
Endokrinium
Beschreibung
Lymphozyten und sehr zahlreiche Plasmazellen infiltrieren das interfollikuläre Stroma und das Follikelepithel. Das Follikelepithel ist am reichlich vorhandenen hellen Zytoplasma erkennbar. Kolloid ist nur noch spärlich vorhanden. Die Epithelzellkerne sind reaktiv vergrössert und enthalten mehrere kleine Nukleolen. Das Kernchromatin ist nicht vergröbert. Einzelne Lymphozyten und Plasmazellen sind im Zytoplasma von Thyreozyten nachweisbar.
Klinik
Die Patientin sucht den Hausarzt auf wegen leichter Schmerzen am Hals rechts. Symptome einer Schilddrüsendysfunktion sind auch auf gezielte Anfrage hin nicht vorhanden. Die Schilddrüse ist deutlich vergrössert. Die laborchemischen Untersuchungen ergeben eine pathologisch erhöhte Konzentration der Peroxidase- und Thyreoglobulin-Antikörper. Die Serumwerte für T4 und T3 sind normal, der Wert für TSH ist erhöht. Die Indikation zur Thyreoidektomie wird wegen der deutlichen Struma gestellt.
Bilder Typ
Histologie
Vergrösserung
400
Alter
46
Geschlecht
unbekannt
Datum
Ersteintrag: 06.05.2002
Update: 04.02.2024